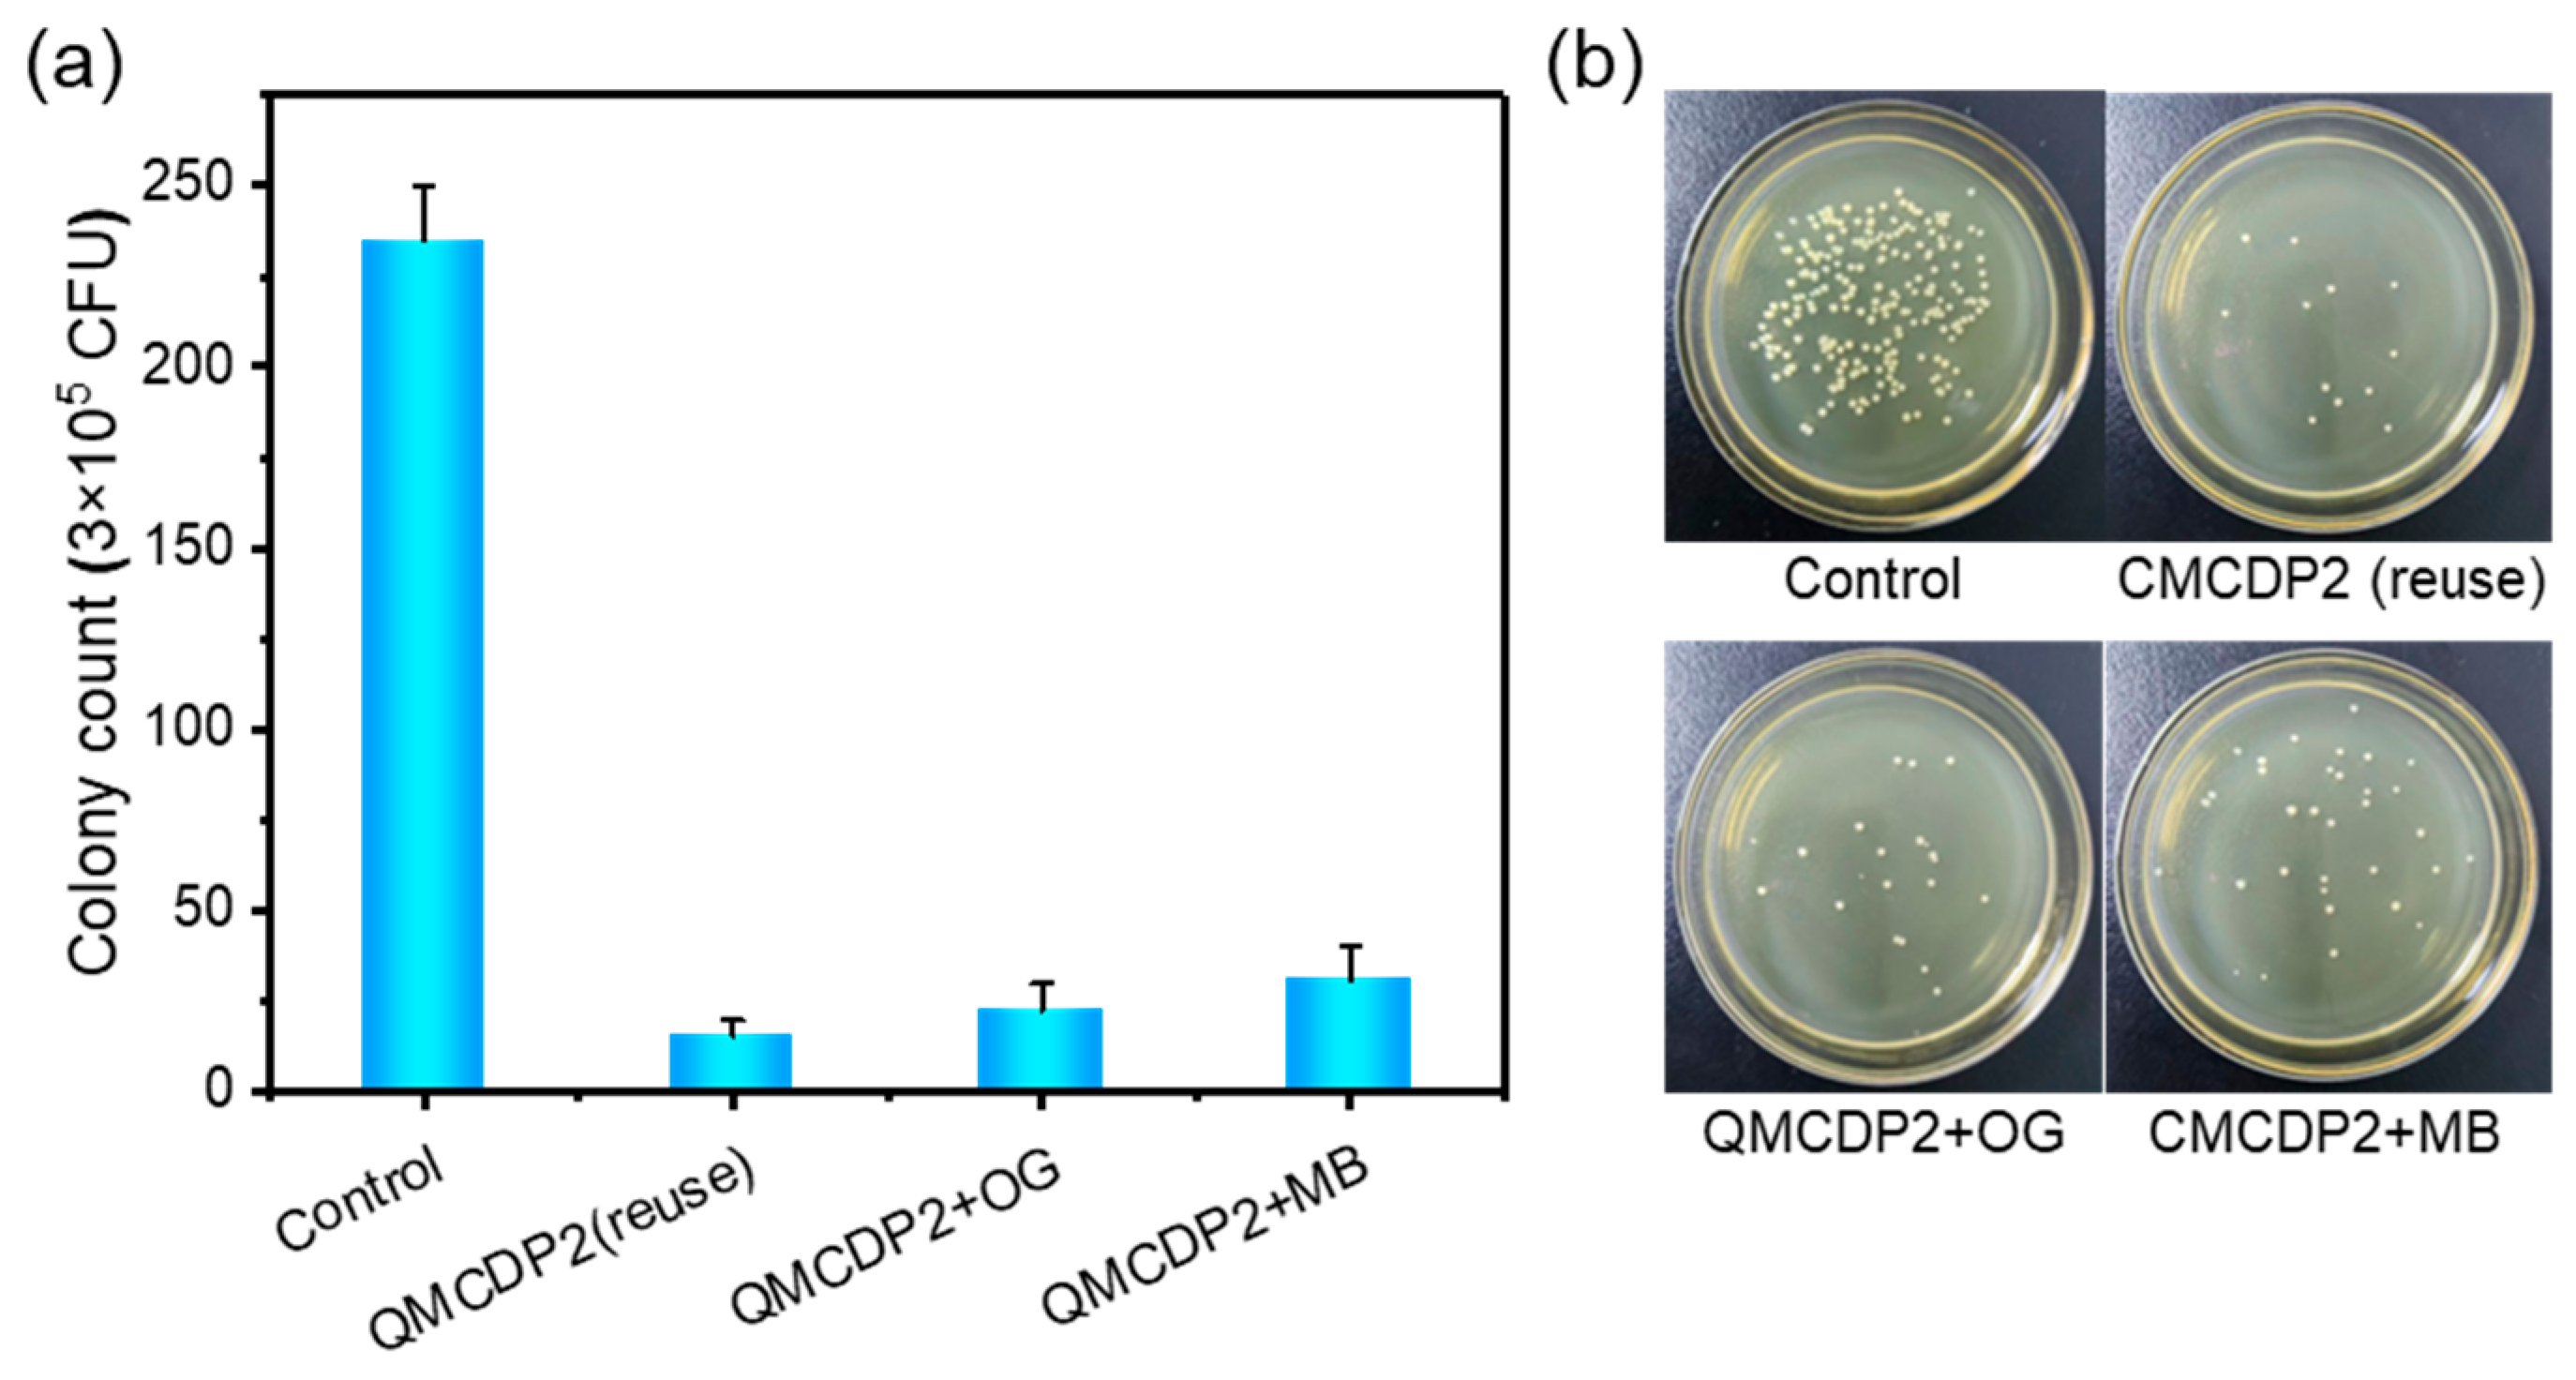
Molecules 28 00167 g011 Molecules 28 00167 g011

Quaternary Ammonium Groups Modified Magnetic Cyclodextrin Polymers for Highly Efficient Dye Removal and Sterilization in Water Purification
Abstract
1. Introduction
2. Results and Discussion
2.1. Characterization of Materials
2.1.1. FT-IR
2.1.2. EA
2.1.3. TGA and Zeta Potential
2.1.4. Magnetism and the Content of MNs in MCDPs
2.1.5. External and Internal Morphology
2.2. Adsorption Isotherm
2.2.1. Anionic Dyes
2.2.2. Electrically Neutral Pollutant
2.3. Adsorption Kinetics
2.4. Influencing Factors of Adsorption
2.5. Adsorption Regeneration
2.6. Antibacterial Performance
3. Materials and Methods
3.1. Materials
3.2. Synthesis of Magnetite Nanoparticles (MNs)
3.3. Synthesis of Magnetic Cyclodextrin Polymer (MCDP)
3.4. Synthesis of QMCDP1
3.5. Synthesis of QMCDP2
3.6. Analytical Methods
3.7. Adsorption Experiment
3.8. Antibacterial Experiment
3.8.1. Plate Counting Experiment
3.8.2. Live Dead Bacteria Staining Test
4. Conclusions
- A series of characterizations demonstrated the successful modification of quaternary ammonium salts and the introduction of positive charges, which are beneficial to anionic dyes’ removal. The maximum adsorption of QMCDP1 and QMCDP2 can reach 85.769 mg·g−1 and 34.775 mg·g−1 for OG and 278.57 mg·g−1 and 174.50 mg·g−1 for MB, respectively, which are both significantly improved relative to the MCDP, which is without quaternary ammonium groups modification.
- Two quaternary ammonium salts with a different length of alkyl chains were introduced to the material, and the one with longer alkyl chain (QMCDP2) removed 99.47% S. aureus from the aqueous environment. Moreover, it still had good bactericidal ability after regeneration, achieving adsorption and antibacterial abilities at the same time, which indicates that QMCDP has great potential and broad application prospects as an antibacterial adsorbent in the field of water treatment.
- Multiple interactions are involved in the adsorption process. The anionic dyes’ removal might be mainly through electrostatic interactions, combined with host–guest interaction in which the quaternary ammonium groups, modified on the surface, took charge. While the adsorption of BPA is primarily through the hydrophobic effect combined with the host–guest interaction, the hydrophobic groups on the surface played the leading role.
Supplementary Materials
Author Contributions
Funding
Institutional Review Board Statement
Informed Consent Statement
Data Availability Statement
Conflicts of Interest
References
- Schwarzenbach, R.P.; Egli, T.; Hofstetter, T.B.; Von Gunten, U.V.; Wehrli, B. Global water pollution and human health. Annu. Rev. Environ. Resour. 2010, 35, 109–136. [Google Scholar] [CrossRef]
- Wang, Q.; Yang, Z. Industrial water pollution, water environment treatment, and health risks in China. Environ. Pollut. 2016, 218, 358–365. [Google Scholar] [CrossRef]
- Han, D.; Currell, M.J.; Cao, G. Deep challenges for China’s war on water pollution. Environ. Pollut. 2016, 218, 1222–1233. [Google Scholar] [CrossRef]
- Kaufman, Y.J.; Tanré, D.; Boucher, O. A satellite view of aerosols in the climate system. Nature 2002, 419, 215–223. [Google Scholar] [CrossRef]
- Ismail, M.; Akhtar, K.; Khan, M.I.; Kamal, T.; Khan, M.A.; Asiri, A.M.; Seo, J.; Khan, S.B. Pollution, toxicity and carcinogenicity of organic dyes and their catalytic bio-remediation. Curr. Pharm. Des. 2019, 25, 3645–3663. [Google Scholar] [CrossRef]
- Homaeigohar, S. The nanosized dye adsorbents for water treatment. Nanomaterials 2020, 10, 295. [Google Scholar] [CrossRef]
- Castillo-Carvajal, L.C.; Sanz-Martín, J.L.; Barragán-Huerta, B.E. Biodegradation of organic pollutants in saline wastewater by halophilic microorganisms: A review. Environ. Sci. Pollut. Res. Int. 2014, 21, 9578–9588. [Google Scholar] [CrossRef]
- Nasar, A.; Mashkoor, F. Application of polyaniline-based adsorbents for dye removal from water and wastewater—A review. Environ. Sci. Pollut. Res. 2019, 26, 5333–5356. [Google Scholar] [CrossRef]
- Zare, E.N.; Motahari, A.; Sillanpää, M. Nanoadsorbents based on conducting polymer nanocomposites with main focus on polyaniline and its derivatives for removal of heavy metal ions/dyes: A review. Environ. Res. 2018, 162, 173–195. [Google Scholar] [CrossRef]
- Hu, Z.-T.; Chen, Y.; Fei, Y.-F.; Loo, S.-L.; Chen, G.; Hu, M.; Song, Y.; Zhao, J.; Zhang, Y.; Wang, J. An overview of nanomaterial-based novel disinfection technologies for harmful microorganisms: Mechanism, synthesis, devices and application. Sci. Total Environ. 2022, 837, 155720. [Google Scholar] [CrossRef]
- Luo, J.; Yu, D.; Hristovski, K.D.; Fu, K.; Shen, Y.; Westerhoff, P.; Crittenden, J.C. Critical review of advances in engineering nanomaterial adsorbents for metal removal and recovery from water: Mechanism identification and engineering design. Environ. Sci. Technol. 2021, 55, 4287–4304. [Google Scholar] [CrossRef]
- Nath, K.; Bhakhar, M.S. Microbial regeneration of spent activated carbon dispersed with organic contaminants: Mechanism, efficiency, and kinetic models. Environ. Sci. Pollut. Res. 2011, 18, 534–546. [Google Scholar] [CrossRef] [PubMed]
- He, Y.; Liu, Y.; Wu, T.; Ma, J.; Wang, X.; Gong, Q.; Kong, W.; Xing, F.; Liu, Y.; Gao, J. An environmentally friendly method for the fabrication of reduced graphene oxide foam with a super oil absorption capacity. J. Hazard. Mater. 2013, 260, 796–805. [Google Scholar] [CrossRef]
- Sharma, V.K.; Johnson, N.; Cizmas, L.; McDonald, T.J.; Kim, H. A review of the influence of treatment strategies on antibiotic resistant bacteria and antibiotic resistance genes. Chemosphere 2016, 150, 702–714. [Google Scholar] [CrossRef]
- Dodd, M.C. Potential impacts of disinfection processes on elimination and deactivation of antibiotic resistance genes during water and wastewater treatment. J. Environ. Monit. 2012, 14, 1754–1771. [Google Scholar] [CrossRef]
- Alsbaiee, A.; Smith, B.J.; Xiao, L.; Ling, Y.; Helbling, D.E.; Dichtel, W. Rapid removal of organic micropollutants from water by a porous β-cyclodextrin polymer. Nat. Cell Biol. 2016, 529, 190–194. [Google Scholar] [CrossRef]
- Liu, Q.; Zhou, Y.; Lu, J.; Zhou, Y. Novel cyclodextrin-based adsorbents for removing pollutants from wastewater: A critical review. Chemosphere 2020, 241, 125043. [Google Scholar] [CrossRef]
- Duan, Z.; Bian, H.; Zhu, L.; Xia, D. Efficient removal of thiophenic sulfides from fuel by micro-mesoporous 2-hydroxypropyl-β-cyclodextrin polymers through synergistic effect. Sep. Purif. Technol. 2022, 300, 121884. [Google Scholar] [CrossRef]
- Tian, B.; Hua, S.; Tian, Y.; Liu, J. Cyclodextrin-based adsorbents for the removal of pollutants from wastewater: A review. Environ. Sci. Pollut. Res. 2021, 28, 1317–1340. [Google Scholar] [CrossRef]
- Li, R.X.; Liu, S.M.; Zhao, J.Q.; Otsuka, H.; Takahara, A. Preparation and characterization of cross-linked β-cyclodextrin polymer/Fe3O4 composite nanoparticles with core-shell structures. Chin. Chem. Lett. 2011, 22, 217–220. [Google Scholar] [CrossRef]
- Sun, L.; Xu, G.; Tu, Y.; Zhang, W.; Hu, X.; Yang, P.; Wu, D.; Liang, Y.; Wei, D.; Li, A.; et al. Multifunctional porous β-cyclodextrin polymer for water purification. Water Res. 2022, 222, 118917. [Google Scholar] [CrossRef] [PubMed]
- Zeng, A.; Zeng, A. Synthesis of a Quaternized Beta Cyclodextrin-Montmorillonite Composite and Its Adsorption Capacity for Cr(VI), Methyl Orange, and p-Nitrophenol. Water Air Soil Pollut. 2017, 228, 278. [Google Scholar] [CrossRef]
- Aryee, A.A.; Mpatani, F.M.; Han, R.; Shi, X.; Qu, L. A review on adsorbents for the remediation of wastewater: Antibacterial and adsorption study. J. Environ. Chem. Eng. 2021, 9, 106907. [Google Scholar] [CrossRef]
- Xiao, L.; Ling, Y.; Alsbaiee, A.; Li, C.; Helbling, D.E.; Dichtel, W.R. β-cyclodextrin polymer network sequesters perfluorooctanoic acid at environmentally relevant concentrations. J. Am. Chem. Soc. 2017, 139, 7689–7692. [Google Scholar] [CrossRef]
- Arslan, M.; Sayin, S.; Yilmaz, M. Removal of carcinogenic azo dyes from water by new cyclodextrin-immobilized iron oxide magnetic nanoparticles. Water Air Soil Pollut. 2013, 224, 1527. [Google Scholar] [CrossRef]
- Rodríguez-López, M.I.; Pellicer, J.A.; Gómez-Morte, T.; Auñón, D.; Gómez-López, V.M.; Yáñez-Gascón, M.J.; Gil-Izquierdo, Á.; Cerón-Carrasco, J.P.; Crini, G.; Núñez-Delicado, E.; et al. Removal of an azo dye from wastewater through the use of two technologies: Magnetic cyclodextrin polymers and pulsed light. Int. J. Mol. Sci. 2022, 23, 8406. [Google Scholar] [CrossRef]
- Liu, Y.-M.; Cui, X.; Hao, C.-M.; Tao, F.-R.; Li, J.-Y. Modified gelatin with quaternary ammonium salts containing epoxide groups. Chin. Chem. Lett. 2014, 25, 1193–1197. [Google Scholar] [CrossRef]
- Kwaśniewska, D.; Chen, Y.-L.; Wieczorek, D. Biological activity of quaternary ammonium salts and their derivatives. Pathogens 2020, 9, 459. [Google Scholar] [CrossRef] [PubMed]
- Yadav, S.; Asthana, A.; Singh, A.K.; Chakraborty, R.; Vidya, S.S.; Susan, A.B.H.; Carabineiro, S.A. Adsorption of cationic dyes, drugs and metal from aqueous solutions using a polymer composite of magnetic/β-cyclodextrin/activated charcoal/Na alginate: Isotherm, kinetics and regeneration studies. J. Hazard. Mater. 2021, 409, 124840. [Google Scholar] [CrossRef]
- Jiang, Y.; Liu, B.; Xu, J.; Pan, K.; Hou, H.; Hu, J.; Yang, J. Cross-linked chitosan/β-cyclodextrin composite for selective removal of methyl orange: Adsorption performance and mechanism. Carbohydr. Polym. 2018, 182, 106–114. [Google Scholar] [CrossRef]
- Mahdavi, M.; Bin Ahmad, M.; Haron, J.; Namvar, F.; Nadi, B.; Ab Rahman, M.Z.; Amin, J. Synthesis, surface modification and characterisation of biocompatible magnetic iron oxide nanoparticles for biomedical applications. Molecules 2013, 18, 7533–7548. [Google Scholar] [CrossRef] [PubMed]
- Chen, H.; Zhou, Y.; Wang, J.; Lu, J.; Zhou, Y. Polydopamine modified cyclodextrin polymer as efficient adsorbent for removing cationic dyes and Cu2+. J. Hazard. Mater. 2020, 389, 121897. [Google Scholar] [CrossRef] [PubMed]
- Zhang, X.; Li, Z.; Lin, S.; Théato, P. Fibrous materials based on polymeric salicyl active esters as efficient adsorbents for selective removal of anionic dye. ACS Appl. Mater. Interfaces 2020, 12, 21100–21113. [Google Scholar] [CrossRef]
- Crini, G. Recent developments in polysaccharide-based materials used as adsorbents in wastewater treatment. Prog. Polym. Sci. 2005, 30, 38–70. [Google Scholar] [CrossRef]
- Zhou, Y.; Hu, Y.; Huang, W.; Cheng, G.; Cui, C.; Lu, J. A novel amphoteric β-cyclodextrin-based adsorbent for simultaneous removal of cationic/anionic dyes and bisphenol A. Chem. Eng. J. 2018, 341, 47–57. [Google Scholar] [CrossRef]
- Soni, H.; Padmaja, P. Palm shell based activated carbon for removal of bisphenol A: An equilibrium, kinetic and thermodynamic study. J. Porous Mater. 2014, 21, 275–284. [Google Scholar] [CrossRef]
- Shuang, C.; Li, P.; Li, A.; Zhou, Q.; Zhang, M.; Zhou, Y. Quaternized magnetic microspheres for the efficient removal of reactive dyes. Water Res. 2012, 46, 4417–4426. [Google Scholar] [CrossRef]
- Hu, X.; Xu, G.; Zhang, H.; Li, M.; Tu, Y.; Xie, X.; Zhu, Y.; Jiang, L.; Zhu, X.; Ji, X.; et al. Multifunctional β-cyclodextrin polymer for simultaneous removal of natural organic matter and organic micropollutants and detrimental microorganisms from water. ACS Appl. Mater. Interfaces 2020, 12, 12165–12175. [Google Scholar] [CrossRef]
- Li, X.; Lu, H.; Zhang, Y.; He, F. Efficient removal of organic pollutants from aqueous media using newly synthe-sized polypyrrole/CNTs-CoFe2O4 magnetic nanocomposites. Chem. Eng. J. 2017, 316, 893–902. [Google Scholar] [CrossRef]
- Liu, F.-F.; Liu, G.-Z.; Zhu, Z.-L.; Wang, S.-C.; Zhao, F.-F. Interactions between microplastics and phthalate esters as affected by microplastics characteristics and solution chemistry. Chemosphere 2019, 214, 688–694. [Google Scholar] [CrossRef]
- Liu, J.; Sun, Z.; Deng, Y.; Zou, Y.; Li, C.; Guo, X.; Xiong, L.; Gao, Y.; Li, F.; Zhao, D. Highly water-dispersible biocompatible magnetite particles with low cytotoxicity stabilized by citrate groups. Angew. Chem. Int. Ed. 2009, 48, 5875–5879. [Google Scholar] [CrossRef] [PubMed]
- Pan, H.; Zhao, T.; Xu, L.; Shen, Y.; Wang, L.; Ding, Y. Preparation of novel chitosan derivatives and applications in functional finishing of textiles. Int. J. Biol. Macromol. 2020, 153, 971–976. [Google Scholar] [CrossRef] [PubMed]
- Song, X.; He, Y.; Pan, X.; Wei, M.; Li, R.; Zhou, X.; Zheng, Y.; Li, J.; Tang, H. Adsorptive Behavior of Methyl Blue on Graphene Aerogel: A Mechanism Study. J. Wuhan Univ. Technol. Mater. Sci. Ed. 2021, 36, 239–242. [Google Scholar] [CrossRef]
- Yao, S.; Lai, H.; Shi, Z. Biosorption of Methyl Blue onto Tartaric Acid Modified Wheat Bran from Aqueous Solution. Iran. J. Environ. Health Sci. Eng. 2012, 9, 16. [Google Scholar] [CrossRef]
- Fan, L.; Luo, C.; Sun, M.; Qiu, H.; Li, X. Synthesis of Magnetic β-Cyclodextrin-Chitosan/Graphene Oxide as Nanoadsorbent and Its Application in Dye Adsorption and Removal. Colloids Surf. B Biointerfaces 2013, 103, 601–607. [Google Scholar] [CrossRef] [PubMed]
- Liu, J.; Liu, G.; Liu, W. Preparation of Water-Soluble β-Cyclodextrin/Poly(Acrylic Acid)/Graphene Oxide Nanocomposites as New Adsorbents to Remove Cationic Dyes from Aqueous Solutions. Chem. Eng. J. 2014, 257, 299–308. [Google Scholar] [CrossRef]
- Tan, P.; Hu, Y. Improved Synthesis of Graphene/β-Cyclodextrin Composite for Highly Efficient Dye Adsorption and Removal. J. Mol. Liq. 2017, 242, 181–189. [Google Scholar] [CrossRef]

| Polymers | N (%) | C (%) | H (%) |
|---|---|---|---|
| MCDP | 3.94 | 35.28 | 3.41 |
| QMCDP1 | 4.70 | 36.59 | 4.49 |
| QMCDP2 | 4.15 | 41.78 | 4.89 |
| Absorbents | Pollutants | Langmuir Model | Freundlich Model | ||||
|---|---|---|---|---|---|---|---|
| qmax (mg·g−1) | kL (L·mg−1) | R2 | n | kF (mg·g−1· (mg·L−1)−n) | R2 | ||
| QMCDP1 | OG | 85.769 | 772.68 | 0.99405 | 0.09391 | 100.17 | 0.74715 |
| QMCDP2 | OG | 34.775 | 980.09 | 0.94565 | 0.01373 | 35.264 | 0.94062 |
| MCDP | MB | 125.88 | 55.705 | 0.98351 | 0.18295 | 151.11 | 0.85785 |
| QMCDP1 | MB | 278.57 | 50.187 | 0.96668 | 0.29739 | 439.91 | 0.91452 |
| QMCDP2 | MB | 174.50 | 102.40 | 0.98901 | 0.19480 | 230.84 | 0.93308 |
| Absorbents | Langmuir Model | Freundlich Model | ||||
|---|---|---|---|---|---|---|
| qmax (mg·g−1) | kL (L·mg−1) | R2 | n | kF mg·g−1·(mg·L−1)−n | R2 | |
| MCDP | 94.650 | 9.4516 | 0.98125 | 0.51619 | 143.31 | 0.94774 |
| QMCDP1 | 52.287 | 11.294 | 0.99570 | 0.41595 | 68.461 | 0.98754 |
| QMCDP2 | 109.65 | 13.595 | 0.99771 | 0.51347 | 197.55 | 0.98279 |
| Absorbents | Pollutants | Pseudo-First-Order Kinetic Model | Pseudo-Second-Order Kinetic Model | ||||
|---|---|---|---|---|---|---|---|
| k1 (min−1) | qe (mg·g−1) | R2 | k2 (g·mg−1·min−1) | qe (mg·g−1) | R2 | ||
| QMCDP1 | OG | 0.25522 | 44.837 | 0.99950 | 3.9291 | 43.887 | 0.99478 |
| QMCDP2 | OG | 0.02182 | 34.312 | 0.99335 | 0.57483 | 31.115 | 0.96131 |
| QMCDP1 | MB | 0.09099 | 75.483 | 0.99346 | 3.2045 | 72.865 | 0.97572 |
| QMCDP2 | MB | 0.02952 | 72.169 | 0.99211 | 1.3175 | 68.249 | 0.96158 |
Disclaimer/Publisher’s Note: The statements, opinions and data contained in all publications are solely those of the individual author(s) and contributor(s) and not of MDPI and/or the editor(s). MDPI and/or the editor(s) disclaim responsibility for any injury to people or property resulting from any ideas, methods, instructions or products referred to in the content. |
© 2022 by the authors. Licensee MDPI, Basel, Switzerland. This article is an open access article distributed under the terms and conditions of the Creative Commons Attribution (CC BY) license (https://creativecommons.org/licenses/by/4.0/).
Share and Cite
Liu, B.; Wang, S.; Wang, H.; Wang, Y.; Xiao, Y.; Cheng, Y. Quaternary Ammonium Groups Modified Magnetic Cyclodextrin Polymers for Highly Efficient Dye Removal and Sterilization in Water Purification. Molecules 2023, 28, 167. https://doi.org/10.3390/molecules28010167
Liu B, Wang S, Wang H, Wang Y, Xiao Y, Cheng Y. Quaternary Ammonium Groups Modified Magnetic Cyclodextrin Polymers for Highly Efficient Dye Removal and Sterilization in Water Purification. Molecules. 2023; 28(1):167. https://doi.org/10.3390/molecules28010167
Chicago/Turabian StyleLiu, Bingjie, Shuoxuan Wang, He Wang, Yong Wang, Yin Xiao, and Yue Cheng. 2023. "Quaternary Ammonium Groups Modified Magnetic Cyclodextrin Polymers for Highly Efficient Dye Removal and Sterilization in Water Purification" Molecules 28, no. 1: 167. https://doi.org/10.3390/molecules28010167
APA StyleLiu, B., Wang, S., Wang, H., Wang, Y., Xiao, Y., & Cheng, Y. (2023). Quaternary Ammonium Groups Modified Magnetic Cyclodextrin Polymers for Highly Efficient Dye Removal and Sterilization in Water Purification. Molecules, 28(1), 167. https://doi.org/10.3390/molecules28010167

